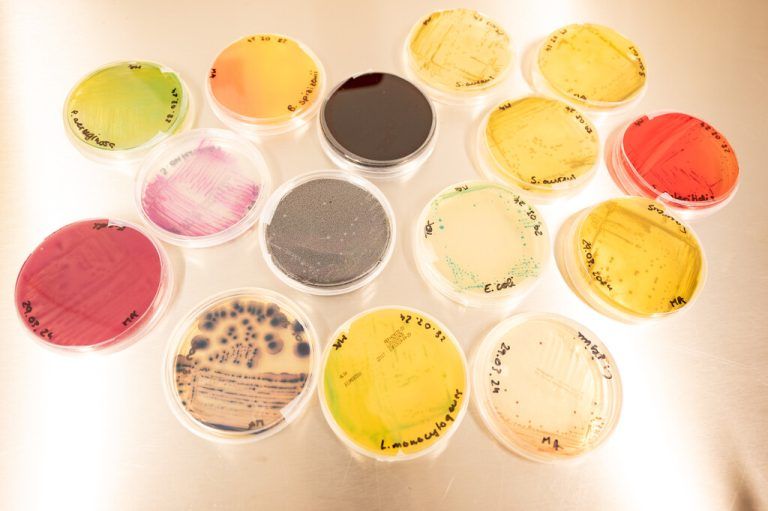

Das Labor für alle Fälle
Am Dienstag gewährte das Institut für Umwelt und Lebensmittelsicherheit einen Einblick in sein breites Aufgabenfeld.
Von Tobias Holzer
tobias.holzer@neue.at
Ein Rückblick auf die Corona-Jahre: Immer wieder sprachen Politiker vom „Abwasser-Monitoring“, mit dem das Infektionsgeschehen i